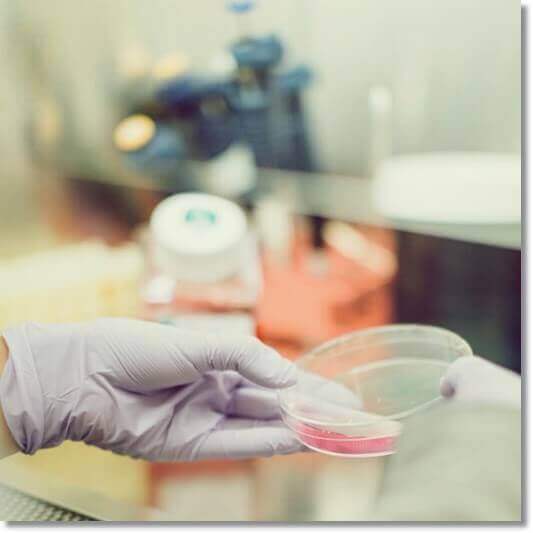

저칼슘혈증 증상, 원인 및 예방과 치료 관리
- 건강, 음식, 효능
- 2023. 10. 18.
칼슘은 뼈 건강에 필수적인 미네랄로 대부분 뼈에 저장되지만, 일부는 혈액을 순환하며 전해질로 사용됩니다. 또한, 부갑상샘 문제나 신장 기능 장애 식이요법, 약물복용 등으로 저칼슘혈증이 발생할 수 있으며, 모르고 지내기도 하지만 근육 경련, 따끔거림. 우울증 등이 생길 수 있습니다. 저칼슘혈증 증상, 원인 및 예방과 치료 관리 등에 대해 알아봅니다.
칼슘 기능 및 저칼슘혈증 수치
칼슘은 우리 몸에서 가장 풍부하면서도 중요한 미네랄로 뼈와 치아를 형성할 뿐만 아니라 혈액 응고를 돕고, 근육과 신경, 심장 기능에도 필요합니다. 칼슘의 약 99%는 뼈에, 나머지 1%는 혈액을 순환합니다. 혈중 칼슘 수치가 과도하게 높으면 조직과 기관에 쌓여 석회질이 생길 수 있지만, 너무 낮으면 저칼슘혈증이 생길 수 있습니다.
목차
- 칼슘 기능 및 저칼슘혈증 수치
- 저칼슘혈증 수치
- 저칼슘혈증 증상
- 저칼슘혈증 원인
- 저칼슘혈증 진단 및 치료
- 저칼슘혈증 예방과 관리
칼슘은 인체에서 가장 풍부한 미네랄로 전체 체중의 1.5~2%를 차지합니다. 성인의 몸에는 약 1,200g의 칼슘이 존재하며 99% 이상이 뼈에서 발견됩니다. 뼈는 정상적인 혈장 칼슘 수치를 유지하기 위해 쉽게 이용할 수 있는 칼슘 공급원으로 50%는 이온화되어 생리학적으로 활성화되어 탈회시켜 저칼슘혈증을 예방할 수 있습니다.
저칼슘혈증 수치
저칼슘혈증은 혈청 칼슘 수치가 낮은 것으로 정상 범위는 일반적으로 2.1~2.6 mmol /L (8.8~10.7mg/dL, 4.3~ 5.2m Eq/L )이며, 혈중 칼슘은 단독으로 이온화되거나 단백질에 결합한 형태로 존재합니다. 또한, 혈장이온화칼슘농도가 4.7㎎/dL(1.17 mmol/L) 이하로 떨어지면 저칼슘혈증으로 진단될 수 있습니다.
저칼슘혈증 증상
저칼슘혈증이 있는 사람도 초기에는 전혀 증상을 보이지 않는 경우가 많지만, 증상이 진행됨에 따라 입 주변이 따끔거리고 손이 저리거나 저린 증상이 나타날 수 있습니다. 또한, 칼슘 수치가 떨어짐에 따라, 근육 경직 및 경련이 흔히 발생하며, 호흡 곤란, 심근 경색과 같은 심장 문제로 이어질 수 있습니다.
칼슘 수치가 과도하게 떨어지면, 피부와 손가락, 발 등에 따끔거림, 근육통, 인후 근육 연축, 근육 경직 및 연축 등의 강직증, 발작, 그뿐만 아니라 부정맥과 혼란, 기억 상실, 섬망, 우울증, 환각과 같은 신경학적, 심리적 증상을 유발할 수 있습니다.
저칼슘혈증 원인
칼슘은 혈액과 같은 체액에 용해될 때 전하를 운반하는 미네랄로 저칼슘혈증은 일반적으로 혈청 칼슘이 소변을 통해 과도하게 배출되거나 뼈에서 혈액으로 들어가는 양이 너무 적을 때 발생하며, 유전적 요인과 신장 기능 저하, 비타민 결핍, 약물복용 등, 다양한 요인으로 발생할 수 있습니다.

혈청 칼슘 수치는 일반적으로 주요 칼슘 조절 호르몬인 부갑상선 호르몬(PTH)과 비타민 D, 칼시토닌 등이 장, 신장, 골격 등에 관여해 (2.1~2.6 mmol/L) 범위 내에서 조절됩니다. 또한, 저칼슘혈증은 부갑상선 호르몬이나 비타민 D 수치가 부적절하거나 호르몬에 대한 저항성 등으로 발생하게 됩니다.
저칼슘혈증 진단 및 치료
저칼슘혈증 진단에는 일반적으로 칼슘 수치를 측정하는 혈액 검사 등을 통해 진단되면 치료는 근본적인 원인과 증상에 따라 다르지만, 칼슘과 비타민 D 보충에 중점을 두고 있으며, 마그네슘도 사용합니다. 부갑상샘기능저하증으로 인한 경우 티아자이드 이뇨제, 인산염 결합제, 저염 및 저인 식단으로 치료할 수 있습니다.

저칼슘혈증 예방과 관리
칼슘은 우유 및 유제품, 달걀, 브로콜리와 같은 녹색 잎채소, 콩류, 견과류, 해조류 멸치와 같은 작은 생선 등에 많이 들어 있으며, 비타민 D가 흡수에 도움이 됩니다. 그러나 다양한 약물이 칼슘 흡수를 저해할 수 있으며 과도한 음주와 카페인도 칼슘 흡수를 방해할 수 있습니다.
'건강, 음식, 효능' 카테고리의 다른 글
| 꿀물 효능 및 영양성분 먹는 법과 주의점 (0) | 2023.10.22 |
|---|---|
| 락토페린 효능 및 구성성분 섭취량과 주의점 (0) | 2023.10.20 |
| 히스타민 불내증 원인 및 증상과 치료 관리 (0) | 2023.10.16 |
| 포스파티딜콜린 효능 및 기능 많은 음식과 주의점 (0) | 2023.10.14 |
| 브로멜라인 효능 및 구성성분, 섭취량과 부작용 (0) | 2023.10.12 |
